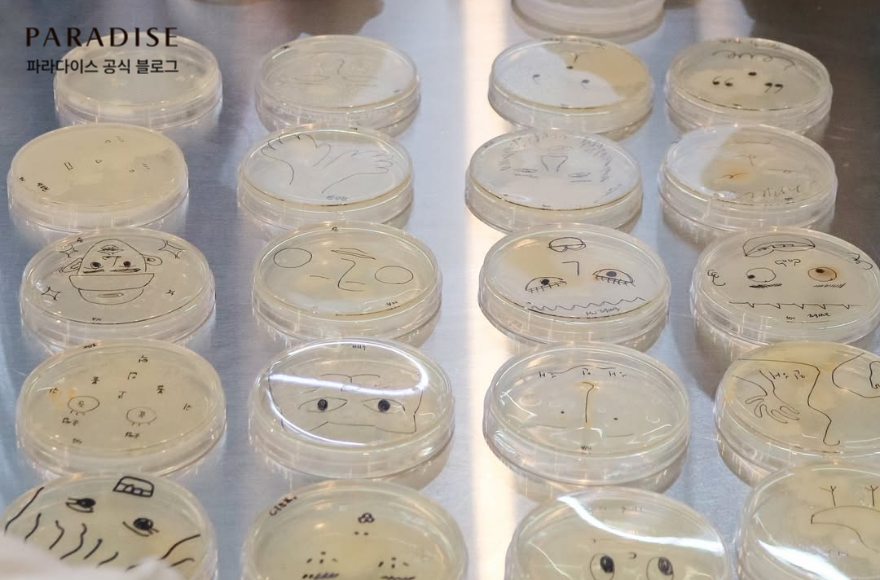

예술과 과학이 만나는 창작의 장, 파라다이스 아트랩 워크숍
예술은 함께 소통하고 공유하며 확장될 때 더 깊어집니다. 파라다이스 아트랩 워크숍에서 펼쳐지는 이야기를 지금 소개합니다. 파라다이스 아트랩 워크숍은 예술가와 기획자, 그리고 관객이 모여 다양한 방식으로 교류하고 탐구하고 실험하며 예술적 가치를 확장하는 커뮤니티 공간입니다. 워크숍 참여자들은 예술을 감상하는 것을 넘어 소통하고 정보를 교환하며, 아이디어를 실험하는 과정을 통해 창작의 의미를 확장합니다. 올해는 ‘바이오아트’를 주제로 계절마다 다양한 프로그램이 이어지고 있는데요. 지금까지는 예술 워크숍, 북 클럽, 스터디, 과학 강연, 기획자 토크 등 다양한 활동이 진행되었고, 다가오는 10월에는 자연 속 관찰과 실험을 일상으로 확장하는 시간이 준비되어 있습니다.
예술과 과학이 만나는 창작의 장, 파라다이스 아트랩 워크숍
지식을 나누고 창작을 실험하는 파라다이스 아트랩 워크숍

파라다이스 아트랩 워크숍은 예술가와 기획자 그리고 관객이 이야기를 나누고 교류하는 장으로 꾸려졌습니다. 강연과 대담에서 시작해 기록과 관찰, 실험과 제작으로 자연스럽게 이어지며 창작의 흐름을 만들어 갑니다. 참여자들은 생명을 예술적 시선으로 바라보고, 과학적 방법을 빌려 작업을 확장시켜 나갑니다. 단순히 체험에 그치지 않고 서로의 질문을 나누고 결과를 공유하면서, 함께 성장하는 커뮤니티 학습이 이어지는 것이 워크숍의 큰 매력입니다.
예술과 과학이 만나는 창작의 장, 파라다이스 아트랩 워크숍
바이오아트로 탐구하는 생명과 예술의 새로운 시도

올해의 주제는 바이오아트(Bio-Art)입니다. 생물학(Biology)과 예술(Art)이 만난 예술장르로, 생명을 매개로 한 예술을 넘어서 생태, 환경, 사회, 정체성 등 폭 넓은 이야기를 다루며 범위와 의미가 확장되고 있습니다. 이번 워크숍은 총 네 개의 챕터로 진행되며, 환경·생명·식물 같은 주제를 다루면서 생명체의 권리와 감수성을 어떻게 예술로 표현할 수 있을지를 고민했습니다. 참여자들은 단순히 이론만 배우는 것이 아니라 자료를 찾아보고, 작은 실험을 설계하고, 결과를 기록하며 자신의 작업에 적용해 보는 과정을 경험하고 있습니다.
예술과 과학이 만나는 창작의 장, 파라다이스 아트랩 워크숍
Chapter1·2: 기초에서 확장으로 이어지는 프로그램
워크숍 시작을 열었던 첫번째 챕터는 바이오아트를 이해하기 위한 기초 시간이었습니다. ‘작은 세포, 큰 발견’ 프로그램에서는 생명의 가장 기본 단위인 '세포'를 예술적 소재로 활용할 수 있는 방법을 모색해보았고, ‘예술가를 위한 생물학’ 세션에서는 창작 활동에 필요한 기본 지식을 쉽게 익혔습니다. 북 클럽에서는 관련 책을 함께 읽고 토론하면서 같은 주제를 바라보는 서로 다른 시각을 나눌 수 있었습니다.
두 번째 챕터에서는 기초 학습을 실제 경험으로 확장했습니다. ‘생물학 장비 기초 실습’에서는 기본적인 실험 도구를 직접 다뤄보며 감각을 익혔고, 진화생물학자 이대한의 강연에서는 생명이 변화해 온 큰 흐름을 이해하는 시간을 가졌습니다. 또한 과학콘텐츠그룹 갈다와 함께한 생물실험실 투어, 허대찬 기획자와 함께한 ‘바이오아트 리서치랩’에서는 참여자들의 관심사를 탐구하는 스터디 프로그램을 진행했습니다.
예술과 과학이 만나는 창작의 장, 파라다이스 아트랩 워크숍
Chapter3: 다양한 제작 실험과 나만의 바이오아트 프로젝트

세 번째 챕터에서는 직접 손으로 만들며 창작을 확장하는 시간이 이어졌습니다. 바이오플라스틱의 재료로 활용되는 스코비(SCOBY, 발효 과정에서 생기는 미생물 덩어리)로 유기적인 주머니를 제작하는 실습, 바이오아트 실천적 사례를 펼치고 있는 커뮤니티 공간 BioClub Tokyo와의 해외교류 활동, 오픈 미생물학 장비를 다뤄보는 체험 등이 마련되었죠.
특히 ‘미니 프로젝트: 나만의 바이오아트 제작’은 참여자들에게 큰 의미가 있었습니다. 총 4회차로 진행된 이 과정에서는 다양한 사례를 살펴보며 아이디어를 얻고, 미생물 배양 실험으로 직접 시도를 이어갔습니다. 이어 일상 속 생명체를 새롭게 바라보는 상상 확장 단계를 거쳐, 마지막에는 개인별 기획안과 작은 프로토타입 작품을 선보였습니다. 결과물은 오는 12월에 파라다이스 아트랩 워크숍 공간에서 전시로 이어질 예정입니다.
예술과 과학이 만나는 창작의 장, 파라다이스 아트랩 워크숍
지식을 나누고 창작을 실험하는 파라다이스 아트랩 워크숍

다가오는 10월 챕터4로 돌아오는 파라다이스 아트랩 워크숍은 자연 속에서의 관찰과 실험을 일상으로 확장하는 시간이 될 예정입니다. 먼저 공원에서 쌍안경으로 새를 관찰하고, 주변에 떨어진 나뭇잎·열매·깃털 등을 기록해보는 ‘팜팜 버드 클럽’는 직접 만든 식물성 잉크와 깃털펜으로 생각을 남기며 자연과 교감하는 경험을 이어갑니다. 또 하나의 프로그램인 ‘술 빚는 하얀 곰팡이’는 쌀이 누룩과 미생물을 만나 전통주가 되어가는 과정을 탐구하고 나만의 취향을 담은 가향주를 디자인해보는 시간을 가집니다. 이외에도 토양 미생물을 가까이서 관찰하는 ‘우리 동네 미생물 아파트 만들기’부터 천문학자에게 듣는 우주생물학과 외계생명체 이야기까지 다채로운 프로그램으로 바이오아트의 가능성을 함께 경험하고 확장해 나갈 예정입니다.
※ 파라다이스 아트랩 워크숍 챕터 4 Info.
-정보: 예약하러 가기
생명을 관찰하고 데이터를 기록하며, 손으로 만들고 서로의 언어로 바꾸는 과정은 예술을 새롭게 바라보게 합니다. 파라다이스 아트랩 워크숍은 예술가와 관객이 만나 아이디어를 나누고, 다양한 방식으로 창작을 시도하는 커뮤니티 프로그램으로 자리잡아 왔습니다. 이번에 소개한 활동에 이어 더 확장해 나가며, 새로운 시도와 만남을 이어갈 예정입니다. 앞으로 펼쳐질 파라다이스 아트랩 워크숍에도 많은 관심과 참여 부탁드립니다.
| 가을 바다의 낭만을 품은 휴식, 파라다이스 호텔 부산에서 즐기는 감성 호캉스 (29) | 2025.10.21 |
|---|---|
| 2026 수능 D-30 찐 꿀팁, 점수를 움직이는 마지막 전략 (0) | 2025.10.14 |
| 파라다이스가 추천하는 추석 선물 스위트룸 휴식부터 향기까지 (0) | 2025.09.24 |
| 파라다이스그룹이 전하는 해피 메모리즈, 따뜻한 변화의 순간들 (1) | 2025.09.18 |
| 처서가 지난 여름의 끝자락, 선선한 바람과 함께 즐기기 좋은 낭만 스팟 추천 (29) | 2025.08.26 |
댓글 영역